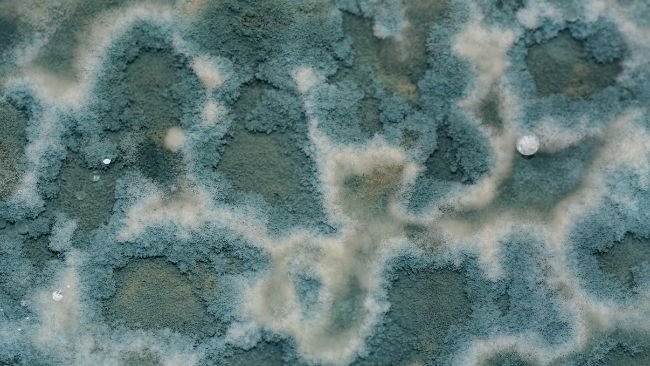

Introducción
Las micotoxinas son metabolitos secundarios producidas por diversos hongos bajo determinadas condiciones. Existen más de 200 micotoxinas conocidas, de las que aproximadamente 12 reciben especial atención. En síntesis, para ganado porcino las principales micotoxinas y sus hongos productores son i) Aflatoxinas (B1, B2, G1, G2) y Ocratoxina A producidas por Aspergillus (esta última también por Penicilium); ii) Tricotecenos (Dioxinivalenol –DON-, Nivalenol, Zearalelona, Fumonisina –B1, B2-, Toxinas T-2 y HT-2) producidos por Fusarium y iii) alcaloides de Ergot producidos por Claviceps. Los efectos negativos de las micotoxinas son específicos para cada una, pero incluyen efectos carcinogénicos, teratogénicos, mutagénicos, hepatotóxicos, inmunosupresivos, nefrotóxicos, neurotóxicos, y estrogénicos. En general, se deben considerar por sus efectos sobre los animales, ya que no suelen dejar residuos en la carne. Actualmente está regulada la Aflatoxina B1 y el cornezuelo del centeno (RD 465/2003 modificada por ORDEN PRE/1809/2006), pero existen recomendaciones (Recomendación de la Comisión 2006/576/CE) para el DON, Zearalelona, Ocratoxina A y Fumonsinas B1+B2. Es un tema extenso y complejo, pero el presente artículo se centrará en cómo minimizar el riesgo de su aparición.

Estrategias de control
Es complejo saber a ciencia cierta el grado de contaminación, pero diversas estimaciones indican que al menos el 25% de la producción mundial de materias primas está contaminada en mayor o menor grado. Por tanto debemos entender que i) son estrategias de control y minimización, no de erradicación, ii) debemos actuar de forma multidisciplinar, no vale con una medida única. A continuación se muestran unas recomendaciones prácticas para el control de la contaminación, aunque debe tenerse en cuenta que i) puede haber hongos y haber o no micotoxinas, y ii) puede haber micotoxinas pero no hongos (las han producido y han muerto).
Estrategias pre-fábrica de pienso

| 1. Medidas fitotécnicas: | ||
|
a. Rotación de cultivos de especies no huéspedes de Fusarium (alfalfa, patatas, remolacha, trébol) entre cereales de invierno. b. Evitar mínimo laboreo. c. Utilización de variedades o híbridos resistentes (u OGM permitidos) y adaptadas al terreno para evitar su debilidad. d. Evitar estrés a la planta: falta de nutrientes (fertilización), heladas o sequía (riego). e. Uso de plaguicidas y fungicidas en las condiciones autorizadas. f. Evitar la superpoblación de plantas, las malas hierbas y el encamado del cereal |
||
|
2. Cosecha y secado: |
||
|
a. Cosecha con la humedad adecuada, ni tempranas (exceso humedad) ni tardías. b. No cosechar cereal encamado y húmedo. c. Secado de cereal: mínimo intervalo entre cosecha y secado (adecuar cosecha a capacidad secadora) a <15% HR, y aireamiento durante almacenaje húmedo. |
||
|
3. Almacenamiento y transporte: |
||
|
a. Almacenamiento adecuado controlando los incrementos de temperatura. b. Limpieza, desinfección, desratización y desinsectación (LDDD) de locales. c. Uso de fungostáticos (por ejemplo ácido propiónico o sus sales) como preventivos, o insecticidas y fungicidas registrados. d. Transporte en medios limpios, frecuentemente desinfectados, y siempre cubiertos para evitar plagas, insectos y lluvia. |
||
Estrategias en fábrica de pienso
| 4. Control de calidad: | ||
|
a. Recepción: Toma de muestras representativa (la contaminación no es homogénea), valorando plagas, granos rotos, granos afectados por hongos, colores o olores extraños, temperatura >10º a la ambiental, humedad máxima en función del cereal. b. Expedición: monitorización de las principales micotoxinas en diferentes tipos de piensos al menos una vez al cuatrimestre y siempre que se sospeche. |
||
| 5. Descarga y almacenamiento: | ||
|
a. Descarga en piquera cubierta, programa de limpieza, desinfección, desratización y desinsectación (LDDD) en piquera y silos. b. Utilización sistemática (o cuando se sospeche) de fungostáticos (por ejemplo ácido propiónico y sus sales, solos o en combinación con otros ácidos) en la descarga. c. Uso inmediato de partidas introducidas con alta humedad, evitar stocks largos. |
||
| 6. Producción: | ||
|
a. Excluir una materia prima sospechosa o limitar su porcentaje de inclusión en las especies o estados fisiológicos más sensibles (ej: lechones, centeno en cerdas gestantes, etc). b. LDDD de locales bajo el sistema de autocontrol (APPCC). Evitar polvo. c. Uso de fungostáticos (por ejemplo ácido propiónico o sus sales) como preventivos en mezcladora (verificar corrosividad del producto usado). d. Los tratamientos térmicos eliminan los hongos, pero no las micotoxinas, ni evitan una recontaminación posterior y su potencial producción (los ácidos orgánicos sí). e. Uso de detoxificantes (aprobados como nueva categoría de aditivos por el Reglamento 386/2009), que reducen la absorción de las micotoxinas (adsorbentes) o modifican su estructura (biotransformadores). Los primeros, entre los que destacan distintos tipos de arcillas y silicatos como el aluminosilicato sódico-cálcico hidratado –HSCAS-, están más extendidos y testados, aunque los estudios in vitro no siempre reproducen los resultados in vivo. Además, la compleja estructura de las micotoxinas implica que un adsorbente puede ser eficaz contra una micotoxina pero no contra el resto (por ejemplo el HSCAS es eficaz contra Aflatoxina B1 pero no contra otras micotoxinas). |
||
| 7. Almacenamiento y expedición: | ||
|
a. Limpieza, desinfección, desratización y desinsectación (LDDD) de locales y silos bajo el sistema de autocontrol (APPCC). b. Expedición cubierta, con el menor acceso posible de plagas. |
||
Estrategias post-fábrica de pienso
| 8. Transporte: | ||
| a. Transporte en medios limpios, frecuentemente desinfectados, y siempre cubiertos para evitar plagas, insectos y lluvia. | ||
| 9. Almacenamiento y distribución en granja: | ||
|
a. Programa LDDD en silos. Minimizar el stock de pienso viejo a la descarga del nuevo. b. Limpieza y mantenimiento de conducciones y comederos. Evitar fermentaciones por exceso de agua en sistemas de tolva en pienso húmedo, y en sistemas de alimentación líquida. |
||
Niveles
A continuación se expone los niveles máximos admitidos:
| Micotoxina | Rango | Nivel, mg/kg1 | Estado | Publicado |
| Aflatoxina B1 | Piensos completos, excepto animales jóvenes | 0,02 | Legislado | RD 465/2003 modificado por Orden Pre 1422/2004 y Orden Pre 1809/2006 |
| Piensos completos, animales jóvenes | 0,01 | |||
| Piensos complementarios, excepto animales jóvenes | 0,02 | |||
| Piensos completos, animales jóvenes | 0,005 | |||
| Deoxinivalenol | Piensos complementarios y completos | 0,9 | Recomendación | Recomendación de la Comisión 2006/576/CE |
| Zearalenona | Piensos complementarios y completos para lechones y cerdas nulíparas | 0,1 | Recomendación | Recomendación de la Comisión 2006/576/CE |
| Piensos complementarios y completos para cerdas y cerdos de engorde | 0,25 | Recomendación | Recomendación de la Comisión 2006/576/CE | |
| Ocratoxina A | Piensos complementarios y completos para cerdos | 0,05 | Recomendación | Recomendación de la Comisión 2006/576/CE |
| Fumonsinas B1+B2 | Piensos complementarios y completos para cerdos | 5 | Recomendación | Recomendación de la Comisión 2006/576/CE |
1ppm con 12% de humedad
Conclusión
El control de micotoxinas es un tema muy complejo, y debe abordarse mediante estrategias multidisciplinares a lo largo de toda la cadena de producción. A nivel práctico las labores se deben centrar en comprar materia prima adecuada, en la producción, almacenamiento y transporte en condiciones higiénicas, y si se quiere mayor seguridad, en el uso de ácidos orgánicos y agentes detoxificantes. Asimismo, en el proceso de adquisición de materia prima, resulta de especial utilidad la compra de materias primas con garantías (evaluación de proveedores, programas conjuntos de control de calidad como Qualimac o gmp.galis). Es un área donde todavía existe mucho desconocimiento, y que en el futuro debe abordar otro aspecto clave: el sinergismo entre micotoxinas.